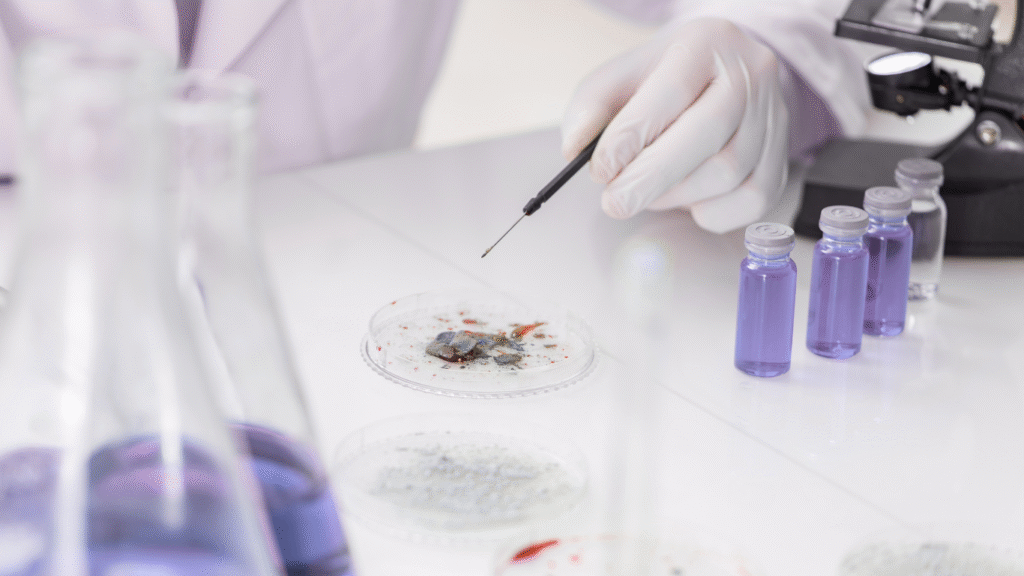

What Is Bisabolol and Why Is It Linked to Skin Brightening?
If you’re into skincare, you’ve probably come across bisabolol – a plant-derived ingredient often praised for its calming effects. But why are some products now marketing bisabolol as a skin brightener? Is there any real science behind these claims, or is it just another overstated buzzword?
Bisabolol is a naturally occurring compound found in chamomile and brak (Vanillosmopsis pohlii). Traditionally used to soothe redness and irritation, bisabolol has recently gained attention for its potential to reduce dark spots and even out skin tone. But what exactly is it doing beneath the surface? This article unpacks the science, the clinical evidence, and how to effectively use bisabolol for skin brightening – without falling for the unproven claims.
- What Is Bisabolol and Why Is It Linked to Skin Brightening?
- How Does Bisabolol Work to Brighten Skin? The Science Behind the Claims
- Optimal Formulation Strategies for Bisabolol as a Skin Brightening Agent
- Potential Risks and Misconceptions: What You Need to Know Before Using Bisabolol for Whitening
- Final Thoughts and Recommendations: Is Bisabolol a Safe and Effective Skin Brightening Ingredient?
How Does Bisabolol Work to Brighten Skin? The Science Behind the Claims
Understanding Melanin: The Root of Pigmentation
To understand how bisabolol works as a skin brightener, we first need to look at how pigmentation forms. Melanin is the pigment that gives skin its color. It’s produced by cells called melanocytes, which are activated when skin is exposed to UV light. Think of melanin as your skin’s natural shield – the darker the spot, the more melanin it contains.
But melanin production isn’t a simple process. It involves several steps, regulated by enzymes like tyrosinase and pathways like cAMP. While many brightening agents work by directly inhibiting tyrosinase (like hydroquinone and kojic acid), bisabolol takes a different, less aggressive approach.
The cAMP Pathway: Bisabolol’s Indirect Route to Brighter Skin
Instead of blocking tyrosinase outright, bisabolol reduces melanin production by targeting the cAMP signaling pathway. This pathway regulates the activity of microphthalmia-associated transcription factor (MITF), a protein that acts as the master switch for melanin production.
Imagine MITF as the “on” switch for pigment production. When bisabolol enters the skin, it downregulates the cAMP pathway, reducing the phosphorylation of CREB (a protein that activates MITF). With less CREB activity, MITF remains in the “off” position, leading to less tyrosinase and, ultimately, less melanin.
Why Is This Important?
Unlike stronger brightening agents that target tyrosinase directly, bisabolol’s mechanism is more gradual and less likely to irritate the skin.
The trade-off? Results may take longer to appear, but the risk of rebound pigmentation – a common side effect of hydroquinone – is significantly lower.
Clinical Evidence: Can Bisabolol Actually Brighten Skin?
Clinical data on bisabolol’s skin-brightening effects is limited but promising. In a study involving 28 Asian women with UV-induced dark spots, participants applied a 0.5% bisabolol cream once daily for 8 weeks. The researchers used spectrophotometry – a technique that measures changes in skin tone – to assess the results.
- Results: After 8 weeks, the bisabolol group showed a 24% reduction in pigmentation compared to baseline. This level of improvement is comparable to mild brightening agents but less pronounced than aggressive treatments like hydroquinone.
- Notable Observations: Participants did not report irritation or dryness, suggesting bisabolol’s suitability for sensitive or post-inflammatory pigmentation.
Key Takeaway: Bisabolol isn’t a rapid fix for dark spots. It’s more of a long-term, skin-friendly option that gradually reduces pigmentation without causing inflammation or barrier disruption.
Optimal Formulation Strategies for Bisabolol as a Skin Brightening Agent
For bisabolol to effectively reduce pigmentation, how it’s formulated matters as much as the concentration. Bisabolol is oil-soluble, meaning it needs a specific delivery system to penetrate the skin effectively without degrading.
The Right Concentration: Finding the Sweet Spot
Clinical studies suggest that a 0.5% concentration of bisabolol is the optimal level for pigmentation reduction. This concentration provided noticeable brightening in clinical trials without triggering irritation.
- Going higher than 0.5% won’t necessarily increase the brightening effect, but it may enhance bisabolol’s anti-inflammatory action.
- For sensitive or reactive skin, starting with a 0.3% concentration and gradually increasing can prevent irritation while allowing skin to acclimate.
Choosing the Best Formulation for Bisabolol
- Liposomal Serums: By encapsulating bisabolol in tiny, lipid-based spheres, liposomal serums protect it from oxidation and enhance penetration. This delivery method is particularly effective for targeting deeper pigmentation.
- Oil-in-Water Emulsions: These formulations combine water and oil phases to maintain hydration while delivering bisabolol effectively. They are ideal for daily use, particularly in dry or sensitive skin.
- Anhydrous Balms: Without water, these formulations are more stable and less prone to oxidation. They are especially suitable for those with a compromised skin barrier or post-inflammatory pigmentation.
Boosting Bisabolol’s Stability and Efficacy
Bisabolol is prone to oxidation, which can reduce its efficacy. To maintain its integrity, look for formulations in airless pumps or opaque packaging. Additionally, pairing bisabolol with stabilizing antioxidants like Vitamin C (ascorbic acid) or Vitamin E (tocopherol) can prevent degradation and amplify its brightening effects.
Pro Tip: For best results, apply a bisabolol serum under a ceramide-rich moisturizer. This combination not only enhances penetration but also protects the skin barrier, minimizing potential dryness or irritation.

Takeaway: The effectiveness of bisabolol as a skin-brightening agent depends on formulation stability, optimal concentration, and supportive ingredients that prevent oxidation and reinforce its calming effects.
Potential Risks and Misconceptions: What You Need to Know Before Using Bisabolol for Whitening
Bisabolol is often positioned as a milder alternative to traditional brightening agents, but it’s not without potential risks and misconceptions. Understanding these nuances can help you make an informed decision about whether bisabolol is right for your skin.
Allergic Reactions and Chamomile Sensitivity: Not as Gentle as It Seems
Bisabolol is derived from chamomile, a member of the Asteraceae family – the same group as ragweed. While chamomile is widely recognized for its calming properties, it can also trigger allergic reactions in people sensitive to these plants. This means that if you’re allergic to ragweed, daisies, or marigolds, bisabolol might not be as soothing as advertised. In fact, contact dermatitis, itching, and redness can occur, particularly when bisabolol is used in higher concentrations or layered with other active ingredients that increase skin permeability.
How to Minimize the Risk:
- Before using bisabolol, apply a small amount to the inner forearm and wait 24 hours. If you notice redness, itching, or swelling, discontinue use.
- Consult a dermatologist if you have known allergies to chamomile or other Asteraceae plants.

Fun Fact: Chamomile is celebrated for its anti-inflammatory properties, but its extracts – including bisabolol – can still provoke allergic reactions in those sensitive to related plants.
Overuse and Sensitization: Why Less Is Often More
Bisabolol is known for its calming effects, but using it excessively or alongside potent actives like AHAs or retinoids can backfire. Imagine your skin as a fragile wall – each active ingredient chips away at its structure. Bisabolol can act as a patch, but too much patching can lead to a weakened barrier.
- Overuse of bisabolol, especially in high concentrations, can overwhelm the skin, leading to dryness or increased sensitivity.
- This is particularly relevant for those already using other exfoliants or brightening agents, as bisabolol may amplify their effects, making the skin more susceptible to irritation.
Pro Tip: If you’re using multiple actives, consider applying bisabolol in the evening when the skin is more receptive to repair and recovery, reducing the risk of daytime irritation.
Unrealistic Expectations: A Slow and Steady Approach
Unlike hydroquinone or kojic acid, bisabolol doesn’t work by directly inhibiting tyrosinase. Instead, it targets the cAMP pathway – a less aggressive, more gradual approach to reducing pigmentation. In clinical studies, a bisabolol cream had a notable brightening effect, but it is not dramatic. Bisabolol works by subtly reducing melanin production without causing the irritation or rebound pigmentation associated with stronger agents.
- Expect results to take 8-12 weeks with consistent use, especially for those with post-inflammatory hyperpigmentation or UV-induced spots.
- If you’re looking for rapid lightening, bisabolol is not the ingredient to reach for. However, its slow, steady action makes it a safer option for those with sensitive or reactive skin.
Takeaway: Bisabolol may not provide immediate brightening, but its cumulative, barrier-friendly approach is ideal for those prioritizing long-term skin health over quick fixes.
Final Thoughts and Recommendations: Is Bisabolol a Safe and Effective Skin Brightening Ingredient?
Bisabolol offers a unique, dual-action approach to skin brightening: it not only reduces pigmentation through the cAMP pathway but also provides antioxidant support to mitigate further oxidative stress. This makes it particularly beneficial for those with sensitive skin or post-inflammatory hyperpigmentation, where harsh brightening agents might exacerbate irritation.
For optimal results, select formulations containing 0.5% bisabolol. This concentration has been clinically studied and shown to reduce pigmentation without triggering adverse reactions. To further enhance its effects, look for products that combine bisabolol with stabilizing antioxidants like Vitamin C (ascorbic acid) or Vitamin E (tocopherol). These ingredients not only prevent bisabolol from oxidizing but also amplify its overall brightening effects.
Packaging matters too. Bisabolol is prone to oxidation, so opt for airless, opaque containers to preserve its efficacy. And remember, bisabolol is a marathon, not a sprint. It works best as part of a consistent, long-term brightening strategy, especially when paired with barrier-strengthening ingredients like ceramides or squalane.

Key Takeaway: Bisabolol isn’t a rapid lightener, but its gentle, cumulative effects make it a valuable option for those seeking gradual brightening without the risk of irritation or rebound pigmentation.
Curious About Bisabolol? Let’s Talk.
Thinking about adding bisabolol to your skincare routine? Start with well-formulated products containing 0.5% bisabolol, ideally combined with antioxidants and barrier-supportive ingredients. Are you unsure about integrating bisabolol with your existing products? Drop your questions below, and let’s talk through the best strategies for your skin. More about bisabolol here.
Your skin deserves the science – let’s make it work for you.
Talk to you soon!
Dr Bozica